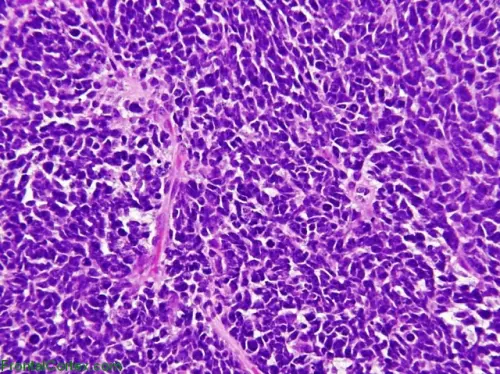
Tumore al Cervello nei Bimbi: 'Stop Molecolare' lo Disinnesca
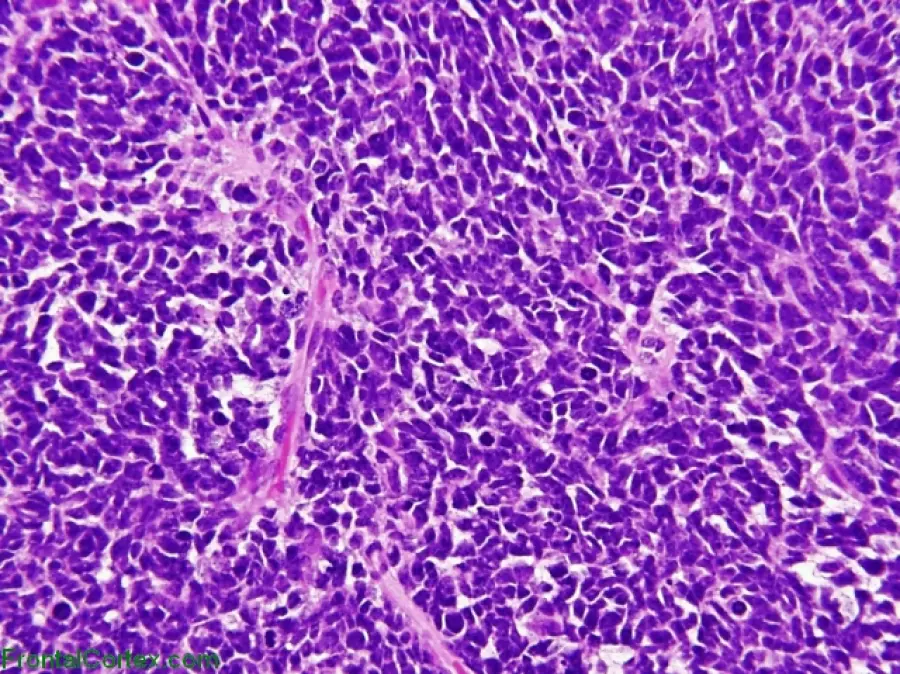
Tumore al Cervello nei Bimbi: 'Stop Molecolare' lo Disinnesca

Tumore al Cervello nei Bimbi: 'Stop Molecolare' lo Disinnesca
di Redazione

E' stato scoperto il modo per bloccare il tumore al cervello più diffuso nei bimbi, il medulloblastoma. Si tratta di uno 'stop molecolare' che ostacola la tremenda patologia
E' stato scoperto il modo per bloccare il tumore al cervello più diffuso nei bimbi, il medulloblastoma. Si tratta di uno 'stop molecolare' che ostacola la tremenda patologia
La scoperta è stata fatta da un'equipe di ricercatori dell'Università 'La Sapienza' di Roma e dell'Istituto Pasteur. I medici hanno capito che bisogna colpire il fulcro del meccanismo neoplastico con determinati medicinali. Le prime sperimentazioni hanno avuto esiti confortanti e, vista la loro importanza, sono stati pubblicati sull'autorevole magazine Developmental Cell.
Oggi il medullobastoma viene contrastato solamente a livello chirurgico e con radioterapia e chemioterapia. I bimbi che sopravvivono, però, devono spesso affrontare pesanti effetti collaterali. La scoperta fatta recentemente, invece, esclude qualsiasi intervento chirurgico: si incide con farmaci specifici a livello molecolare, ovvero si blocca il meccanismo che favorisce la proliferazione delle cellule tumorali.
Esplicative sono indubbiamente le parole di Gianluca Canettieri, responsabile del gruppo di ricerca: "In una percentuale significativa di pazienti il medulloblastoma è causato dall'abnorme attivazione della cosiddetta via di Hedgehog (HH): una sorta di domino molecolare che, in condizioni non controllate, culmina nelle proliferazione e migrazione delle cellule nervose. In questi soggetti abbiamo osservato anche un accumulo di poliammine, cioè piccole molecole a carica positiva che, in genere, aumentano in caso di tumore".
Una volta appresa la dinamica, i ricercatori sono intervenuti con medicinali ad hoc, disattivando così le suddette molecole. I primi test, condotti sugli animali, hanno dato risultati entusiastici. Ora toccherà alle sperimentazioni sull'uomo. Speriamo che anche in tal caso i risultati siano confortanti, perché se così fosse si potrebbero delineare terapie personalizzate per determinati tumori.
Articolo Precedente
Compra Online Risparmiando: ora è possibile con almigliorprezzo.eu



